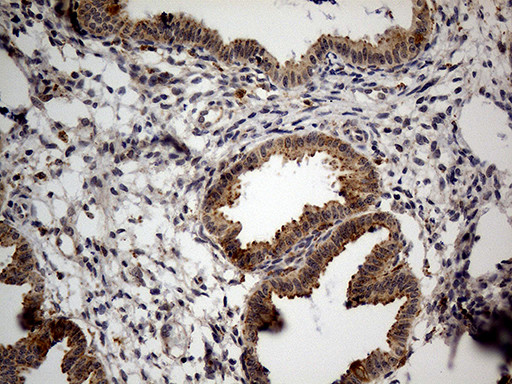
NAGA Antibody in Immunohistochemistry (Paraffin) (IHC (P))

Search
OriGene
NAGA Monoclonal Antibody (OTI3A4), TrueMAB™
{{$productOrderCtrl.translations['antibody.pdp.commerceCard.promotion.promotions']}}
{{$productOrderCtrl.translations['antibody.pdp.commerceCard.promotion.viewpromo']}}
{{$productOrderCtrl.translations['antibody.pdp.commerceCard.promotion.promocode']}}: {{promo.promoCode}} {{promo.promoTitle}} {{promo.promoDescription}}. {{$productOrderCtrl.translations['antibody.pdp.commerceCard.promotion.learnmore']}}
产品信息
TA811320
种属反应
宿主/亚型
分类
类型
克隆号
抗原
偶联物
形式
浓度
纯化类型
保存液
内含物
保存条件
运输条件
靶标信息
NAGA (N-acetylgalactosaminidase, alpha), also known as alpha-galactosidase B or GALB, is a 411 lysosomal protein belonging to the glycosyl hydrolase 27 family that may exist as a homodimer and plays a critical role in glycolipid breakdown. NAGA encodes alpha-N-acetylgalactosaminidase, a lysosomal enzyme, which cleaves alpha-N-acetylgalactosaminyl groups from glycoconjugates. Mapping to human chromosome 22q13. 2, NAGA defects are the cause of an autosomal recessive disorder with three phenotypes, known as Schindler disease (types I, II and III) or NAGA deficiency (types I, II and III). Characterized by neurologic manifestations that range in severity, Schindler disease type I is the most severe form, followed by type III, which may have mild-to-moderate effects. Schindler disease type II, also known as Kanzaki disease, is characterized by mild intellectual impairment and angiokeratoma corporis diffusum.
仅用于科研。不用于诊断过程。未经明确授权不得转售。
篇参考文献 (0)
生物信息学
蛋白别名: Acetylgalactosaminidase, alpha-N- (alpha-galactosidase B); Alpha-galactosidase B; Alpha-N-acetylgalactosaminidase; EC 3.2.1; EC 3.2.1.49; galactosidase-alphaB; galactosidasealphaB; N-acetylgalactosaminidase, alpha-
基因别名: D22S674; GALB; NAGA
UniProt ID: (Human) P17050
Entrez Gene ID: (Human) 4668